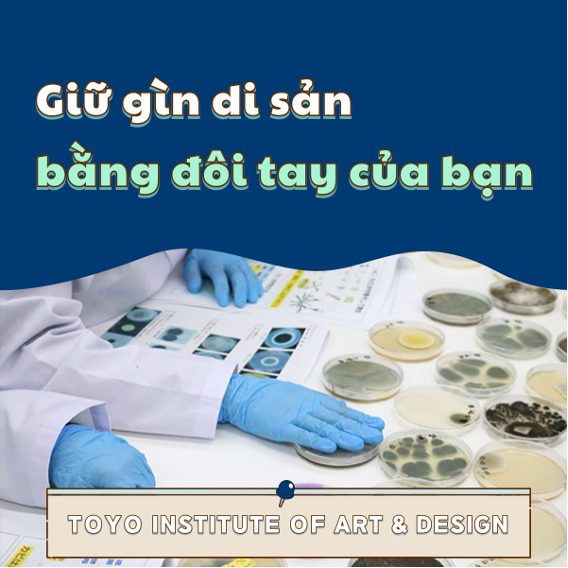
10.png

【東洋美術学校】"Khoa Bảo tồn và Phục hồi" - Học các kỹ năng kết nối thời gian với tương lai
Đối mặt với những tác phẩm nghệ thuật vượt thời gian
Trong một xưởng vẽ yên tĩnh, đầu cọ vẽ vẽ nên một vết nứt tinh tế,
và bàn tay chuyển động như thể để khẳng định những "ký ức" ẩn sâu bên dưới.
Tại Khoa Bảo tồn và Phục chế của Trường Nghệ thuật Toyo, sinh viên không chỉ đơn thuần "sửa chữa" những đồ vật bị hỏng.
Họ học các kỹ thuật và tinh thần để "kết nối" thời gian và suy nghĩ của con người được thể hiện trong các tác phẩm nghệ thuật với tương lai.
Điều này không chỉ bao gồm việc "sáng tạo" nghệ thuật, mà còn "bảo tồn" nó, một hình thức khác của cái đẹp.
Tại đây, bạn sẽ tìm thấy những cơ hội học tập vững chắc để giúp bạn đạt được điều này.





Sinh viên tốt nghiệp truyền lại "Ký ức của đôi tay"
Sinh viên tốt nghiệp Khoa Bảo tồn và Phục chế đang hoạt động tích cực trong thế giới thực, làm việc tại các bảo tàng, phòng trưng bày nghệ thuật và các công ty phục chế tài sản văn hóa.
Rio Aoyama, người đặc biệt thu hút sự chú ý trong lĩnh vực phục chế tranh sơn dầu, hiện đang thực hiện dự án trùng tu Đền Torin cổ kính trong thời gian học cao học sau khi tốt nghiệp.
"Bảo vệ tài sản văn hóa không phải là sửa chữa chúng, mà là lưu giữ ký ức của những người sống ở đó."
Lời nói của cô thể hiện "thái độ xem xét kỹ lưỡng và làm việc cẩn thận" mà cô đã vun đắp tại Trường Nghệ thuật Tokyo.
"Công nghệ x Nghệ thuật" được trưng bày trong Triển lãm Tác phẩm Sinh viên
Một điểm nổi bật khác của khoa là vô số cơ hội cho sinh viên sáng tạo và trình bày tác phẩm của mình ngay khi còn đang đi học.
Hiện tại, triển lãm "Những cuốn sách bạn vẫn có thể đọc sau 100 năm: Báo cáo phục hồi Thư viện Uchida Kakuchi năm 2025" đang được tổ chức tại Thư viện và Bảo tàng Hibiya, giới thiệu các dự án phục hồi sách đóng bìa theo phong cách phương Tây do sinh viên Khoa Bảo tồn và Phục hồi thực hiện.
Tại trường chúng tôi, sinh viên có thể học tập một cách hệ thống sáu lĩnh vực bảo tồn và phục hồi trong bốn năm.
Sinh viên cũng có được "kinh nghiệm phục hồi xã hội" thông qua các dự án như bảo tồn các bản vẽ manga gốc và các hoạt động phục hồi sau thảm họa.
Các lớp học dạy "cảm xúc" vượt ra ngoài "kỹ thuật".
Tại Khoa Bảo tồn và Phục hồi, sinh viên được học lý thuyết và thực hành phục hồi từng bước, làm việc với nhiều loại vật liệu, bao gồm tranh vẽ, tác phẩm điêu khắc, tài liệu giấy và đồ gá.
Năm nhất: Lý thuyết và các kỹ thuật cơ bản cần thiết cho việc bảo tồn và phục hồi.
Năm hai: Thực hành phục hồi tập trung vào tranh Nhật Bản và tranh sơn dầu.
Năm tư: Nghiên cứu tốt nghiệp tập trung vào tranh cuộn treo, đồ gá và tranh in.
→ Kết quả cuối cùng được trình bày tại một triển lãm tốt nghiệp.
Trong những giờ học thực hành, nơi học viên tương tác với các di sản văn hóa thực tế,
học viên được tương tác với các tác phẩm nghệ thuật, ghi lại từng thay đổi trong tác phẩm, trong những lớp học tràn ngập mùi cọ vẽ, bay và keo dán.
"Hãy cân nhắc kỹ lưỡng ngay cả những chi tiết vô hình."
Đây chính là tinh thần mà Trường Nghệ thuật Toyo trân trọng nhất.

"Bảo tồn văn hóa bằng chính đôi tay của mình" là một lối sống có thể trở thành sự nghiệp tương lai của bạn.
Khuôn viên trường chúng tôi cung cấp một môi trường hỗ trợ cho việc ứng dụng thực tế, bao gồm phòng thí nghiệm phục chế, phòng trưng bày và triển lãm nghiên mực Đan Khê.
Chúng tôi luôn chào đón sinh viên quốc tế, cung cấp chương trình hỗ trợ tiếng Nhật toàn diện và các bài giảng đặc biệt về bối cảnh văn hóa.
Ngay cả những sinh viên mới học tiếng Nhật cũng có thể tự tin đương đầu với thử thách này.
Sau khi tốt nghiệp, bạn sẽ có rất nhiều lựa chọn nghề nghiệp, bao gồm cả sự nghiệp trong lĩnh vực phục chế tài sản văn hóa và mỹ thuật tại Nhật Bản, hoặc bảo tồn di sản văn hóa tại quê nhà.
Bạn cũng có thể lấy bằng "Chuyên gia Cao cấp" và theo đuổi chứng chỉ "quản lý".
Bước tiếp theo là bảo tồn văn hóa cho tương lai.
Công việc phục chế tài sản văn hóa không phải là bảo tồn "vẻ đẹp hiện tại", mà là bảo tồn "giá trị sẽ được các thế hệ tương lai trải nghiệm".
Nếu bạn muốn trau dồi kỹ năng trong khi trải nghiệm những di sản văn hóa đích thực tại Nhật Bản, hoặc muốn theo đuổi sự nghiệp bảo tồn văn hóa, thì việc học tại Khoa Bảo tồn và Phục hồi là bước khởi đầu chắc chắn.
Kết nối văn hóa với tương lai thông qua đôi tay, sự quan sát và cảm xúc của bạn.
Tại đây, bạn sẽ tìm thấy môi trường và những cơ hội cần thiết để thực hiện điều đó.
Tại Trường Nghệ thuật Toyo, tại sao không khám phá một hình thức cái đẹp mới không chỉ "sáng tạo" mà còn "bảo tồn" văn hóa?
Hãy bắt đầu hành trình của bạn tại sự kiện mở cửa khuôn viên trường của chúng tôi.
▶ Trải nghiệm lớp học – Ngày tư vấn – Tư vấn ngày thường
Trường thường xuyên tổ chức các buổi học thử về thiết kế, minh họa, 3DCG, manga, nghệ thuật…
Hãy đến và trải nghiệm để khám phá “công việc tương lai” của bạn!
►︎ Xem thêm thông tin tại:
https://www.to-bi.ac.jp/dept/cdc/
<Hướng dẫn tuyển sinh du học sinh năm 2026>
https://www.to-bi.ac.jp/international/
★ Thời gian bắt đầu nhận hồ sơ là từ ngày 1 tháng 9.
Buổi phỏng vấn sẽ được thực hiện trực tuyến (hoặc trực tiếp tại trường nếu bạn đang sống gần Tokyo), sau khi điều chỉnh lịch trình giữa giảng viên và thí sinh.
Thời lượng phỏng vấn khoảng 15 đến 20 phút, với hình thức 1 thí sinh và 2–3 giảng viên tham gia.
★ Nộp tác phẩm / portfolio
・Nếu bạn có tác phẩm hoặc portfolio, vui lòng nộp dưới dạng file PDF (địa chỉ nộp sẽ được thông báo riêng).
・Chấp nhận cảtác phẩm kỹ thuật số và tác phẩm vẽ tay.
・Khi nộp, vui lòng ghi rõ thời gian sáng tác, phần mềm sử dụng và thời gian thực hiện.
・Lưu ý: Các tác phẩm đã nộp sẽ không được hoàn trả.
Comments
登録されたコメントがありません。



